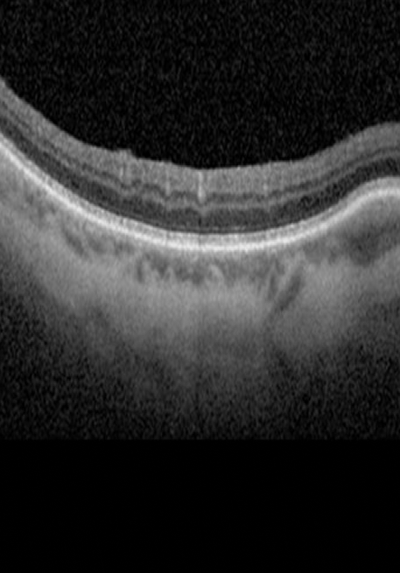

Get new perspectives with the Heidelberg Engineering Account. Sign up to access exclusive resources and insights.
To make sure you don't miss any news, sign up for our newsletter!
We are committed to providing quick, reliable solutions that support your work and help enable high-quality patient care and research.
SPECTRALIS® is a multimodal imaging platform that combines confocal scanning laser ophthalmoscopy with spectral domain OCT. It delivers exceptional image quality and outstanding reproducibility for confident clinical decision-making.

Every SPECTRALIS® contains the core DNA for exceptional image quality, reproducibility, workflow flexibility, and long-term upgradability. The combination of confocal scanning laser ophthalmoscopy, SD-OCT, and patented real-time image processing technologies enables confident visualisation of pathology and individualised patient care.


“TruTrack Active Eye Tracking is an absolutely essential feature for high image quality and accurate follow-up of OCT measurements. Without this feature we would be less confident about our diagnosis. Nothing compares with the excellent image quality of the SPECTRALIS.”

"What stands out is the clarity of the images – I have been really surprised by how brilliant the resolution is. The repeatability of the images we capture is so important, and with SPECTRALIS the repeatability is incredible. The qualities of the SPECTRALIS absolutely help when providing good patient care. We have a large proportion of elderly patients who have very little issue with OCT and infrared fundus imaging, despite the extra chair time, as there is no bright flash and no need for pupil dilation. The modular functionality of SPECTRALIS has also been helpful to us as a business, giving us the ability to bolt on new technology, such as glaucoma monitoring or OCT Angiography. Being able to do this without having to buy an entirely new scanner is a nice position to be in."

The SPECTRALIS® confocal scanning laser ophthalmoscope (cSLO) i is an innovative technology for imaging the retina and other eye structures. Combining the selectivity of laser light with the pinpoint resolution of confocal scanning, the cSLO provides image detail and clarity not available from fundus photography. The cSLO technology not only offers documentation of clinical findings but also often highlights critical diagnostic details not visible on traditional clinical ophthalmoscopy. Since cSLO imaging minimises the effects of light scatter, it can be used effectively even in patients with media opacities or small pupils.

Capture high-definition images that enhance clinical confidence with patented TruTrack Active Eye Tracking. TruTrack uses a second laser beam to actively track the fundus during OCT scanning in real time, mitigating the effects of eye motion, and allowing image capture even during blinks. Additional clinical benefits of TruTrack are retinal thickness measurement reproducibility to 1 micron and excellent image quality throughout the volume scan. This superior performance delivers effective patient management, high- quality images, and reliable follow-up, even in patients with eyes that are traditionally challenging to scan.


Facilitating the capture of high-quality images is SPECTRALIS® Noise Reduction. Noise Reduction is a proprietary technology that captures multiple images in the exact same anatomic location to remove the noise inherent in OCT and scanning laser imaging. By averaging up to 100 B-scans in real-time, Noise Reduction can differentiate structural information from noise and deliver high contrast images of exceptional detail, even in volume scans.

SHIFT is an exclusive technology that optimises performance without sacrificing image quality to deliver individualised patient care. SHIFT, combined with the other SPECTRALIS core technologies, enables you to switch between different scan speeds to find the optimal balance between speed and workflow efficiency. Adapt the examination to the specific needs of your patient with the flexibility to increase the speed when more rapid image acquisition is beneficial or decrease the speed for the capture of clinically meaningful images even in challenging cases.

Using the SPECTRALIS® fundus image like a map, the AutoRescan function automatically places follow-up scans in precisely the same position, visit after visit. Accurate and objective placement of follow-up scans is important for optimising clinic workflow and for confident recognition of the small structural changes that are critical to the effective management of many ophthalmic conditions. Studies have shown that SPECTRALIS with AutoRescan technology can reliably measure changes in retinal thickness as small as 1 micron.

The unique combination of SPECTRALIS® imaging modalities provides the additional information you need to make confident clinical decisions. Build a multimodality imaging device based on your clinical requirements and use various imaging techniques simultaneously to improve your understanding of different pathologies. Benefit from deep clinical insight and efficient workflows without needing to move patients between devices and examination rooms.

SPECTRALIS® is a truly flexible and upgradeable imaging platform. Customise SPECTRALIS precisely to your individual needs, confident in the knowledge that your imaging platform has the capability to grow with your clinic. As new technology becomes available, you can simply add new imaging modalities to your SPECTRALIS that provide additional diagnostic information for enhanced clinical decision-making. Many upgrades can be seamlessly integrated into the platform, without the need to invest in new devices, preserving patient data for precise follow-up, and future-proofing your investment.
SPECTRALIS® provides high-resolution OCT images for visualising 10 layers of the retina.Reliably detect small or significant changes and pinpoint pathology in the individual retinal layers to build confidence in your diagnoses.



